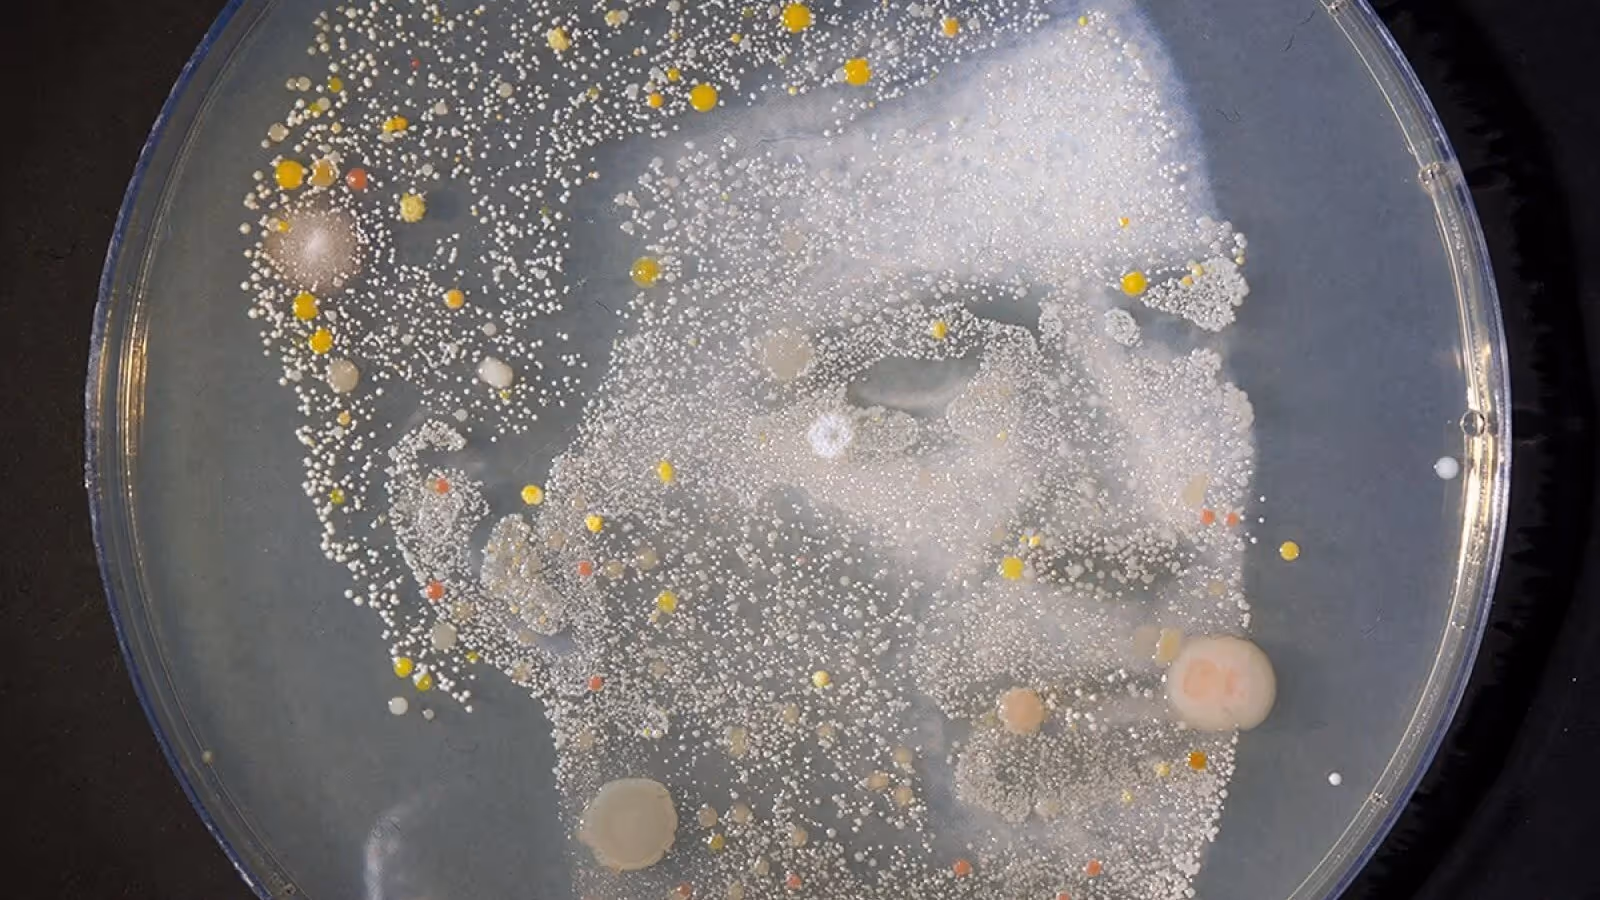
Art exhibition

A grand exposition!

From the 27th to the 29th of October, Capital & Centric’s very own Talbot Mill is hosting a festival of the North West’s most exciting art and we've arranged an exclusive viewing night on the 26th of October!
The event is in conjunction with Capital & Centric, Manchester Science Festival and Cornbrook Creative, and 'A Grand Exposition' will deliver an art exhibition with a difference! As well as displaying some exciting installations, the event promises talks and discussions, and things to make and do. The weekend is dedicated to educating and inspiring through a contemporary stitching together of art and science.
Some of the artists include Manchester based Logan and Wilcox who will display their experimental audio-visual installation ‘Verrfast’ (pictured below). Through using headsets and heart rate monitors, data is collected which prompts a sonic and visual performance. This means participants are able to impact the sounds and images produced through controlling their thoughts and heart rate. Having completed live visual sets at Parklife and Bluedot festivals, Logan and Wilcox’s interactive and pioneering installation is nothing short of a visual feast.

Moving from monitors to microbes, with the work of Jon Biddulph we can see just how groundbreaking and varied the work on show will be. As a result of on-going experiments with Manchester Metropolitan University, Biddulph has created ‘Microbe Me’ (shown below) microbe self-portraits which are mapped onto agar plates with the aim to challenge the idea that man and nature can be separated.
With free access during the daytime it'll be an exciting day out in the historic Talbot Mill. With food, drink, and music aplenty come along and get stuck into something completely unique!
For an invite, please visit the eventbrite by clicking here.







